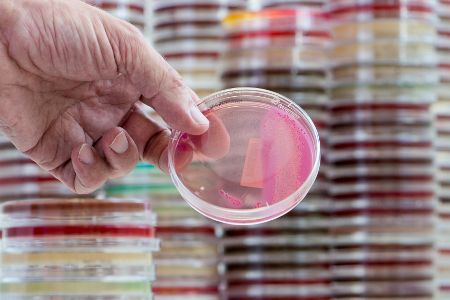
Keime

Auf der Suche nach wirksamen Mitteln gegen Krankenhauskeime haben Forscherinnen und Forscher durch den Einsatz von Künstlicher Intelligenz ein vielversprechendes Antibiotikum entdeckt.

Auf der Suche nach wirksamen Mitteln gegen Krankenhauskeime haben Forscherinnen und Forscher durch den Einsatz von Künstlicher Intelligenz ein vielversprechendes Antibiotikum entdeckt.

Entdeckt wurde das neue Antibiotikum von einem Team aus Wissenschaftlerinnen und Wissenschaftlern des Massachusetts Institute of Technology (MIT) und der McMaster University.

Dieser bahnbrechende Fortschritt könnte einen bedeutenden Schritt in der Entwicklung neuer Medikamente darstellen.
Multiresistente Bakterien, umgangssprachlich "Krankenhauskeime" genannt, stellen eine ernsthafte Bedrohung dar, da sie gegen viele bekannte Antibiotika resistent sind und schnell neue Resistenzmechanismen entwickeln können.

Unter diesen gefährlichen Bakterien ist Acinetobacter baumannii einer der gefährlichsten Erreger, der Lungenentzündungen, Meningitis und andere schwere Krankheiten verursachen kann und auch über längere Zeiträume auf Oberflächen überleben kann.

Bei der Suche nach einem Wirkstoff gegen Acinetobacter baumannii haben die Forschenden ein speziell entwickeltes Machine-Learning-Modell verwendet, das auf Laborergebnissen basiert, bei denen das Bakterium mit rund 7.500 verschiedenen Substanzen in Kontakt gebracht wurde.

Mithilfe des Modells wurden einige hundert Kandidaten ausgewählt, die dann in klassischen Bakterienkulturen auf ihre Wirksamkeit getestet wurden.

Dank dieser KI-gestützten Vorauswahl konnten Tausende potenzieller Wirkstoffe auf nur wenige Hundert reduziert werden.

Durch die klassischen Tests haben die Forschenden einen äußerst effektiven Wirkstoff identifiziert, der gegen Acinetobacter baumannii wirkt und den sie Abaucin genannt haben.

Obwohl weitere Daten noch erforderlich sind, deuten die bisherigen Ergebnisse darauf hin, dass Künstliche Intelligenz eine wichtige Rolle bei der beschleunigten Entwicklung und Entdeckung neuer Medikamente spielen kann.